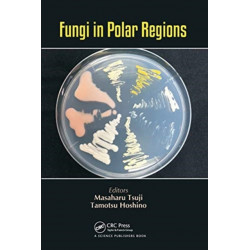
Fungi in Polar Regions

Ingen varer
Der er 5 underkategorier
Klimaregioner
Visning: Type : Alle | Sprog : Alle | Format : Alle
-
Bemærk: Kan ikke leveres før jul.
Ultimate Spotlight: Polar Animals (Bog, Hardback, Engelsk)Polar bears, penguins, and arctic foxes are some of the amazing animals featured in this compelling and interactive book. Ultimate Spotlight books combine moveable parts with fascinating facts and detailed illustrations to provide an engaging inside look at various subjects.
Levering: 6 - 9 hverdage -
Bemærk: Kan ikke leveres før jul.
Tropical Ecosystems and Ecological Concepts (Bog, Paperback / softback, Engelsk)This introductory textbook covers the entire range of tropical ecosystems – terrestrial, freshwater and marine – and uses each system to illustrate and... Læs mere
Levering: Print on Demand (forvent 14 - 30 hverdage) -
Bemærk: Kan ikke leveres før jul.
Snow Widows: Scott’S Fatal Antarctic Expedition Through the Eyes of the Women They Left Behind (Bog, Hardback, Engelsk)‘An elegant, densely textured work, like a tapestry … A welcome contribution to polar studies.’ Sara Wheeler, Spectator ‘[MacInness] handles the whole thing with masterly skill…takes us to the heart of the hope, love, anguish and grief’ The Times
Levering: 6 - 9 hverdage -
Bemærk: Kan ikke leveres før jul.
Polar Tourism: An Environmental Perspective (Bog, Paperback / softback, Engelsk)This book draws attention to the problems and issues surrounding fast-growing tourism in the highly sensitive wilderness areas of polar regions. The authors... Læs mere
Levering: Skaffevare (forvent 14 - 30 hverdage) -
B. J. Harrison Reads The Swiss Family Robinson (Lydbog, zip_mp3, Engelsk)
William and Elizabeth are aboard a ship, together with their four sons, when a storm breaks out. William prays for their salvation, but this does not seem to... Læs mere
PRIS151,- krLevering: Straks (Leveres på e-mail) -
Bemærk: Kan ikke leveres før jul.
Insatiable Appetite: The United States and the Ecological Degradation of the Tropical World (Bog, Paperback / softback, Engelsk)Traces the transformation of the tropics in modern times. Exploring the central role of the US in the... Læs mere
Levering: Print on Demand (forvent 14 - 30 hverdage) -
Bemærk: Kan ikke leveres før jul.
The A to Z of the Inuit (Bog, Paperback / softback, Engelsk)Levering: Print on Demand (forvent 14 - 30 hverdage) -
Bemærk: Kan ikke leveres før jul.
Fungi in Polar Regions (Bog, Paperback / softback, Engelsk)Fungi that inhabit polar-regions can grow and decompose organic compounds under subzero temperatures and play an important role in the nutrient cycle of polar-region ecosystems.... Læs mere
Levering: Skaffevare (forvent 14 - 30 hverdage) -
Bemærk: Kan ikke garanteres før jul.
Arctic Cinemas: Essays on Polar Spaces and the Popular Imagination (Bog, Paperback / softback, Engelsk)Provides a transnational overview of the variety of works - ranging from art films and documentaries to horror and road movies - that fall under the conceptual rubric of ‘Arctic cinemas’, and examines their contributions to past and present perceptions of the Arctic.
Status: Skaffevare (forvent 3 - 8 uger) -
Bemærk: Kan ikke leveres før jul.
Avati: Discovering Arctic Ecology (Bog, Paperback / softback, Engelsk)From the many animals that live and hunt at the floe edge, to the hundreds of insects that abound on the summer tundra, Avati gives a detailed bird's-eye view of the fascinating ways that animals, plants, and insects co-exist in the Arctic ecosystem.
Levering: 6 - 9 hverdage -
Bemærk: Kan ikke leveres før jul.
Junior Field Guide: Fishes of Nunavut: English Edition (Bog, Paperback / softback, Engelsk)Levering: 6 - 9 hverdage -
Bemærk: Kan ikke leveres før jul.
Junior Field Guide: Land Mammals: English Edition (Bog, Paperback / softback, Engelsk)Levering: Skaffevare (forvent 14 - 30 hverdage)

 for at udvide
kategorilisten.
for at udvide
kategorilisten.